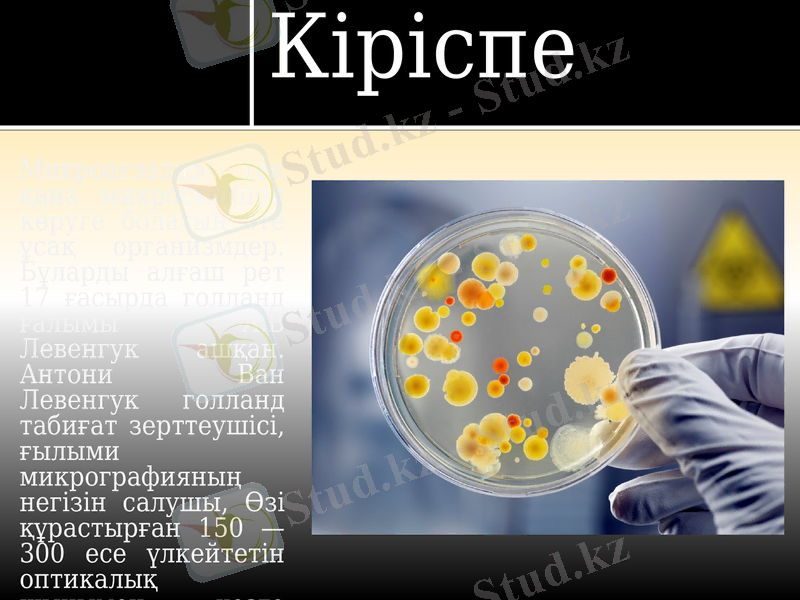
Slide 3

Табиғаттағы микроағзалардың әсері және олардың физиологиялық-биохимиялық қасиеттері



СӨЖ Тақырыбы: Табиғатта микроағзалардың әсері.
ҚАЗАҚСТАН БІЛІМ ЖӘНЕ ҒЫЛЫМ МИНИСТІРЛІГІ
Семей қаласының Шәкәрім атындағы мемлекеттік университеті
«Стандарттау және Биотехнология» кафедрасы
Тексерген: Бейсембаева Г. Ш. Тұрарбек Т. М. Орындаған: Мырзагалиева А. Е. Топ: БТ-507 Семей 2017 жыл

Жоспар:
I. Кіріспе
Микроағзалар
II. Негізгі бөлім
1. Микроағзалардың пайда болуы
2. Физиологиялық және биохимиялық қасиеттері
3. Табиғатта микроағзалардың әсері
4. Абиотикалық, биотикалық факторлар
5. Зиянды микроағзалар
III. Қорытынды
IV. Пайдаланылған әдебиеттер.
Кіріспе
Микроағзалар- тек қана микроскоппен көруге болатын өте ұсақ организмдер. Бұларды алғаш рет 17 ғасырда голланд ғалымы А. В Левенгук ашқан. Антони Ван Левенгук голланд табиғат зерттеушісі, ғылыми микрографияның негізін салушы, Өзі құрастырған 150 - 300 есе үлкейтетін оптикалық шынымен көзге көрінбейтін қарапайымдар, бактериялар, эритроциттерді микроскоп арқылы көрген.

Негізгі бөлім

Антони ван Левенгук
Антони ван Левенгук (нидер. Antoni van Leeuwenhoek, нидер. Thonius Philips van Leeuwenhoek; 24 қазан 1632, Делфт - 26 тамыз 1723, Делфт) - Нидерландлық микробиолог, микроскоптардың алғашқы конструкторы, ғылыми Микроскопияның негіздеушісі, 1680 жылдан бастап Лондон королдік қоғамының мүшесі.

Микроағзалардың пайда болуы
Микроағзаның өздігінен пайда болуы 18 ғасырда ғалымдар арасында көптеген тартыс тудырған тіршіліктің өздігінен пайда болу мәселесіне көп үлес қосқан. Микроағзаның тіршіліктегі орны. Бірақ 19ғ 2-жартысында неміс биологы Геккель микроағзалар мүлдем ұқсамайтындығын және оларды жеке топтастыру қажет екендігін айтады. Сөйтіп микроағзалар жануарлар тобынан жеке бөлініп алынады. Көптеген микроағзаның жағдайы түсініксіз шығу тегі белгісіз және микроағзалар морфологиялық жағынан ерекше. Микроағзаларды атау бинарлық номенклатура 1760 ж К. Линней ашқан. Туыстық деңгейі, түрлік сонымен қатар халық ішілік атауда және паразитті түрлердің қожайындарының атаулары да және цифрмен атауда қолданған.

Физиологиялық және биохимиялық қасиеттері
Физиологиялық және биохимиялық қасиеттері: Микроорганизмдер физиологиялық және биохимиялық қасиеттері олардың кейбіреулері басқа организмдер өніп-өсе алмайтын ортада тіршілік етуге бейімделген. Мысалы, 70 - 1050С ыстықта, жоғары деңгейдегі радиацияда және концентрациясы өте күшті қышқылды (pH<1, 0) немесе сілтілі (рН 9, 0 болатын, кейде одан да жоғары) орталарда, NaCl-дың жоғары концентрациясында (25 - 30%), оттек жоқ жерде (анаэробты жағдайда) тіршілік ете алатын микроорганизмдер белгілі. Олар өте төмен температурада да, құрғақшылық ортада да көбейе алады. Кейбір бактериялар мен балдырлар өз клеткасына қажетті барлық заттарды синтездеу үшін СО2-ні пайдаланады, бұларды автотрофтар деп атайды. Бұлардың ішіндегі кейбіреулері (мысысалы, сүт қышқылы бактериялары және қарапайымдылар) өздерінің дамуына қажетті өсу факторларын, яғни дайын витаминдер, амин қышқылдары немесе т. б. органикалық заттарды өздері синтездей алмайды.

Табиғатта микроағзалардың әсері
Микроағзалардың әлемі өте бай және әр қилы. Табиғатта микроағзалардың өте ұсақ тобы ультрамикробтар да кездеседі. Микроағзалардың бұл тобының ішінен бактериофагтар, сүзілуші вирустардың адам өмірінде зор маңызы бар. Вирустардың шамасы миллиметрдің миллиондаған бөлігіне тең, яғни оларды миллимикрондармен немесе микромикрондармен өлшейді. Олар топырақта, суда және ауда кең тараған. Олардың кең таралуы табиғатта кез-келген нәрсені қорек етуіне, тіршілік ортасына тез бейімделгіш келуі, яғни ыстыққа да, суыққа да, ылғалдың тапшылығына төзімділік танытуы себепші болады

Микроорганизмдерге сыртқы ортаның факторларының әсері.
Микроорганизмдер жердің барлық геологиялық сфераларында - литосферада, гидросферада, атмосферада табылады. Бұлардың екеуі микроорганизмдер сақталатын және тіршілік ететін орталар, ал үшіншісі - уақытша мекендеу және таралу ортасы. Табиғатта микроорганизмдерге абиотикалық факторлармен қатар олармен бірге тіршілік ететін организмдер, биотикалық факторлар да әсер етеді.

Абиотикалық факторлар
Абиотикалық факторлар - бұл организмдерді қоршаған тіршіліксіз орта, яғни оларға организмдер тіршілік ететін табиғи ортаның жағдайларын жатқызады. Микроорганизмдерге климаттық факторлар (температура, жарық, ылғал) мен ортаның физикалық-химиялық жағдайлары (рН, оттек, осмостық қысым, еріген қор заттарының концентрациясы, сұйық-сұйық және сұйық- қатты фаза шекарасы) әсер етеді. Биосфераның абиотикалық компоненттері организмдер тіршілігін тежеп немесе реттеп отырады. Ортаның нақты компоненттерінің жетіспейтін немесе артық мөлшері организмнің өсуін тежейді немесе лимиттейді. Сондықтан организмдердің орта факторларына қатынасын олардың минималды және максималды көрсеткіштері бойынша сипаттайды. Бұл көрсеткіштерден тірі организмдердің қолайлы өсуі үшін қажетті оптимум зонасын бөліп алуға болады. Ауытқу оптимум зонасынан неғұрлым алшақ байқалса, соғұрлым олардың организмге тежегіш әсерлері айқын байқалады. Минимум және максимум арасындағы диапозон организмдердің тіршілік ету немесе толеранттылық (төзімділік) шегін анықтайды.

Биотикалық факторлар
- Іс жүргізу
- Автоматтандыру, Техника
- Алғашқы әскери дайындық
- Астрономия
- Ауыл шаруашылығы
- Банк ісі
- Бизнесті бағалау
- Биология
- Бухгалтерлік іс
- Валеология
- Ветеринария
- География
- Геология, Геофизика, Геодезия
- Дін
- Ет, сүт, шарап өнімдері
- Жалпы тарих
- Жер кадастрі, Жылжымайтын мүлік
- Журналистика
- Информатика
- Кеден ісі
- Маркетинг
- Математика, Геометрия
- Медицина
- Мемлекеттік басқару
- Менеджмент
- Мұнай, Газ
- Мұрағат ісі
- Мәдениеттану
- ОБЖ (Основы безопасности жизнедеятельности)
- Педагогика
- Полиграфия
- Психология
- Салық
- Саясаттану
- Сақтандыру
- Сертификаттау, стандарттау
- Социология, Демография
- Спорт
- Статистика
- Тілтану, Филология
- Тарихи тұлғалар
- Тау-кен ісі
- Транспорт
- Туризм
- Физика
- Философия
- Халықаралық қатынастар
- Химия
- Экология, Қоршаған ортаны қорғау
- Экономика
- Экономикалық география
- Электротехника
- Қазақстан тарихы
- Қаржы
- Құрылыс
- Құқық, Криминалистика
- Әдебиет
- Өнер, музыка
- Өнеркәсіп, Өндіріс
Қазақ тілінде жазылған рефераттар, курстық жұмыстар, дипломдық жұмыстар бойынша біздің қор #1 болып табылады.



Ақпарат
Қосымша
Email: info@stud.kz